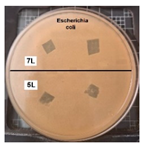
Coatings 14 01211 i001
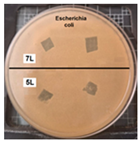
Coatings 14 01211 i003
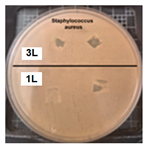
Coatings 14 01211 i006

Antibacterial Activity of Superhydrophobic-SiO2 Coatings to Inhibit the Growth of Escherichia coli and Staphylococcus aureus
Abstract
1. Introduction
2. Methodology
2.1. Materials
2.2. Equipment
2.3. Synthesis and Characterization
2.4. Antibacterial and Bacteriostatic Study
3. Results
3.1. WCA and WSA
3.2. SEM
3.3. TEM
3.4. EDS
3.5. FTIR Spectroscopy
3.6. XRD
3.7. Antimicrobial Activity
4. Discussion
5. Conclusions
Author Contributions
Funding
Institutional Review Board Statement
Informed Consent Statement
Data Availability Statement
Conflicts of Interest
References
- Privett, B.J.; Youn, J.; Hong, S.A.; Lee, J.; Han, J.; Shin, J.H.; Schoenfisch, M.H. Antibacterial fluorinated silica colloid superhydrophobic surfaces. Langmuir 2011, 27, 9597–9601. [Google Scholar] [CrossRef] [PubMed]
- Ashok, D.; Taheri, M.; Garg, P.; Webb, D.; Parajuli, P.; Wang, Y.; Funnell, B.; Taylor, B.; Tscharke, D.C.; Tsuzuki, T.; et al. Shielding surfaces from viruses and bacteria with a multiscale coating. Adv. Sci. 2022, 9, 2201415. [Google Scholar] [CrossRef] [PubMed]
- Schmidt, M.G.; Attaway, H.H.; Sharpe, P.A.; John, J.; Sepkowitz, K.A.; Morgan, A.; Fairey, S.E.; Singh, S.; Steed, L.L.; Cantey, J.R.; et al. Sustained reduction of microbial burden on common hospital surfaces through introduction of copper. J. Clin. Microbiol. 2012, 50, 2217–2223. [Google Scholar] [CrossRef] [PubMed]
- Zarb, P.; Coignard, B.; Griskeviciene, J.; Muller, A.; Vankerckhoven, V.; Weist, K.; Goossens, M.; Vaerenberg, S.; Hopkins, S.; Catry, B.; et al. The European Centre for Disease Prevention and Control (ECDC) pilot point prevalence survey of healthcare-associated infections and antimicrobial use. Eurosurveillance 2012, 17, 20316. [Google Scholar] [CrossRef]
- Ashok, D.; Cheeseman, S.; Wang, Y.; Funnell, B.; Leung, S.-F.; Tricoli, A.; Nisbet, D. Superhydrophobic surfaces to combat bacterial surface colonization. Adv. Mater. Interfaces 2023, 10, 2300324. [Google Scholar] [CrossRef]
- Donlan, R.M. Biofilms: Microbial life on surfaces. Emerg. Infect. Dis. 2002, 8, 881–890. [Google Scholar] [CrossRef]
- Kokare, C.R.; Chakraborty, S.; Khopade, A.N.; Mahadik, K.R. Biofilm: Importance and applications. Indian J. Biotechnol. 2009, 8, 159–168. [Google Scholar]
- Stewart, P.S.; Costerton, J.W. Antibiotic resistance of bacteria in biofilms. Lancet 2001, 358, 135–138. [Google Scholar] [CrossRef]
- Poole, K. Mechanisms of bacterial biocide and antibiotic resistance. J. Appl. Microbiol. 2002, 92 (Suppl. S1), 55s–64s. [Google Scholar] [CrossRef]
- Zhang, X.; Wang, L.; Levänen, E. Superhydrophobic surfaces for the reduction of bacterial adhesion. RSC Adv. 2013, 3, 12003–12020. [Google Scholar] [CrossRef]
- Zhang, C.; McAdams, D.A., 2nd; Grunlan, J.C. Nano/micro-manufacturing of bioinspired materials: A review of methods to mimic natural structures. Adv. Mater. 2016, 28, 6292–6321. [Google Scholar] [CrossRef] [PubMed]
- Wang, L.; Guo, X.; Zhang, H.; Liu, Y.; Wang, Y.; Liu, K.; Liang, H.; Ming, W. Recent advances in superhydrophobic and antibacterial coatings for biomedical materials. Coatings 2022, 12, 1469. [Google Scholar] [CrossRef]
- Berendjchi, A.; Khajavi, R.; Yazdanshenas, M.E. Fabrication of superhydrophobic and antibacterial surface on cotton fabric by doped silica-based sols with nanoparticles of copper. Nanoscale Res. Lett. 2011, 6, 594. [Google Scholar] [CrossRef] [PubMed]
- Falde, E.J.; Yohe, S.T.; Colson, Y.L.; Grinstaff, M.W. Superhydrophobic materials for biomedical applications. Biomaterials 2016, 104, 87–103. [Google Scholar] [CrossRef]
- Dimitrakellis, P.; Ellinas, K.; Kaprou, G.D.; Mastellos, D.C.; Tserepi, A.; Gogolides, E. Bactericidal action of smooth and plasma micro-nanotextured polymeric surfaces with varying wettability, enhanced by incorporation of a biocidal agent. Macromol. Mater. Eng. 2021, 306, 2000694. [Google Scholar] [CrossRef]
- Ciasca, G.; Papi, M.; Businaro, L.; Campi, G.; Ortolani, M.; Palmieri, V.; Cedola, A.; De Ninno, A.; Gerardino, A.; Maulucci, G.; et al. Recent advances in superhydrophobic surfaces and their relevance to biology and medicine. Bioinspir. Biomim. 2016, 11, 011001. [Google Scholar] [CrossRef]
- Crick, C.R.; Ismail, S.; Pratten, J.; Parkin, I.P. An investigation into bacterial attachment to an elastomeric superhydrophobic surface prepared via aerosol assisted deposition. Thin Solid Film 2011, 519, 3722–3727. [Google Scholar] [CrossRef]
- Marmur, A. Super-hydrophobicity fundamentals: Implications to biofouling prevention. Biofouling 2006, 22, 107–115. [Google Scholar] [CrossRef]
- Erbil, H.Y. Practical applications of superhydrophobic materials and coatings: Problems and perspectives. Langmuir 2020, 36, 2493–2509. [Google Scholar] [CrossRef]
- Sreekantan, S.; Hassan, M.; Sundera Murthe, S.; Seeni, A. Biocompatibility and cytotoxicity study of polydimethylsiloxane (PDMS) and palm oil fuel ash (POFA) sustainable super-hydrophobic coating for biomedical applications. Polymers 2020, 12, 3034. [Google Scholar] [CrossRef]
- Feng, L.; Li, S.; Li, Y.; Li, H.; Zhang, L.; Zhai, J.; Song, Y.; Liu, B.; Jiang, L.; Zhu, D. Super-hydrophobic surfaces: From natural to artificial. Adv. Mater. 2002, 14, 1857–1860. [Google Scholar] [CrossRef]
- Mahadik, S.A.; Pedraza, F.; Mahadik, S.S.; Relekar, B.P.; Thorat, S.S. Biocompatible superhydrophobic coating material for biomedical applications. J. Sol-Gel Sci. Technol. 2017, 81, 791–796. [Google Scholar] [CrossRef]
- Liang, Z.; Geng, M.; Dong, B.; Zhao, L.; Wang, S. Transparent and robust SiO2/PDMS composite coatings with self-cleaning. Surf. Eng. 2020, 36, 643–650. [Google Scholar] [CrossRef]
- Zhang, Z.; Xu, C.; Liu, W.; Wang, K.; Rao, Y.; Jiang, C.; Li, D.; Zhang, Y.; Jiang, X.; Chen, X.; et al. Ultrasonic assisted rapid preparation of superhydrophobic stainless steel surface and its application in oil/water separation. Ultrason. Sonochem. 2021, 81, 105848. [Google Scholar] [CrossRef]
- Zhao, Y.; Huo, M.; Huo, J.; Zhang, P.; Shao, X.; Zhang, X. Preparation of silica-epoxy superhydrophobic coating with mechanical stability and multifunctional performance via one-step approach. Colloids Surf. A Physicochem. Eng. Asp. 2022, 653, 129957. [Google Scholar] [CrossRef]
- Ye, H.; Zhu, L.; Li, W.; Liu, H.; Chen, H. Constructing fluorine-free and cost-effective superhydrophobic surface with normal-alcohol-modified hydrophobic SiO2 nanoparticles. ACS Appl. Mater. Interfaces 2017, 9, 858–867. [Google Scholar] [CrossRef]
- Alavi, M.; Thomas, S.; Sreedharan, M. Modification of silica nanoparticles for antibacterial activities: Mechanism of action. Micro Nano Bio Asp. 2022, 1, 49–58. [Google Scholar] [CrossRef]
- Wang, F.; Pi, J.; Song, F.; Feng, R.; Xu, C.; Wang, X.-L.; Wang, Y.-Z. A superhydrophobic coating to create multi-functional materials with mechanical/chemical/physical robustness. Chem. Eng. J. 2020, 381, 122539. [Google Scholar] [CrossRef]
- Xue, F.; Shi, X.; Bai, W.; Li, J.e.; Li, Y.; Zhu, S.; Liu, Y.; Feng, L. Enhanced durability and versatile superhydrophobic coatings via facile one-step spraying technique. Colloids Surf. A Physicochem. Eng. Asp. 2022, 640, 128411. [Google Scholar] [CrossRef]
- Liu, X.; Zhou, Z.; Chen, M.; Liu, Z.; Jiang, S.; Wang, L. Preparation of durable superhydrophobic coatings based on discrete adhesives. Coatings 2024, 14, 463. [Google Scholar] [CrossRef]
- Stöber, W.; Fink, A.; Bohn, E. Controlled growth of monodisperse silica spheres in the micron size range. J. Colloid Interface Sci. 1968, 26, 62–69. [Google Scholar] [CrossRef]
- Quéré, D. Wetting and roughness. Annu. Rev. Mater. Res. 2008, 38, 71–99. [Google Scholar] [CrossRef]
- Prakash, C.G.J.; Prasanth, R. Approaches to design a surface with tunable wettability: A review on surface properties. J. Mater. Sci. 2021, 56, 108–135. [Google Scholar] [CrossRef]
- Stuart, B.H. Infrared Spectroscopy: Fundamentals and Applications; Wiley: Hoboken, NJ, USA, 2004. [Google Scholar]
- Zhuravlev, L.T. The surface chemistry of amorphous silica. Zhuravlev model. Colloids Surf. A Physicochem. Eng. Asp. 2000, 173, 1–38. [Google Scholar] [CrossRef]
- Lee, H.; Dellatore, S.M.; Miller, W.M.; Messersmith, P.B. Mussel-inspired surface chemistry for multifunctional coatings. Science 2007, 318, 426–430. [Google Scholar] [CrossRef] [PubMed]
- Zhu, Y.; Murali, S.; Cai, W.; Li, X.; Suk, J.W.; Potts, J.R.; Ruoff, R.S. Graphene and graphene oxide: Synthesis, properties, and applications. Adv. Mater. 2010, 22, 3906–3924. [Google Scholar] [CrossRef]
- Coates, J. Interpretation of Infrared Spectra, a Practical Approach. In Encyclopedia of Analytical Chemistry; Wiley: Chichester, UK, 2006. [Google Scholar]
- Musić, S.; Filipović-Vinceković, N.; Sekovanić, L. Precipitation of amorphous SiO2 particles and their properties. Braz. J. Chem. Eng. 2011, 28, 89–94. [Google Scholar] [CrossRef]
- Cullity, B.D.; Stock, S.R. Elements of X-ray Diffraction, 3rd ed.; Pearson: Upper Saddle River, NJ, USA, 2014. [Google Scholar]
- Das, P.; Ganguly, S.; Bose, M.; Mondal, S.; Choudhary, S.; Gangopadhyay, S.; Das, A.K.; Banerjee, S.; Das, N.C. Zinc and nitrogen ornamented bluish white luminescent carbon dots for engrossing bacteriostatic activity and Fenton based bio-sensor. Mater. Sci. Eng. C 2018, 88, 115–129. [Google Scholar] [CrossRef]
- Zhou, H.; Persson, C.; Donzel-Gargand, O.; Engqvist, H.; Xia, W. Structural Si3N4-SiO2 glass ceramics with bioactive and anti-bacterial properties. J. Eur. Ceram. Soc. 2024, 44, 4260–4271. [Google Scholar] [CrossRef]
- Villegas, M.; Bayat, F.; Kramer, T.; Schwarz, E.; Wilson, D.; Hosseinidoust, Z.; Didar, T.F. Emerging strategies to prevent bacterial infections on titanium-based implants. Small 2024, 2404351. [Google Scholar] [CrossRef]
- Yu, M.; Cui, Z.; Ge, F.; Man, C.; Lei, L.; Wang, X. Fabrication of durable and roughness-regeneration superhydrophobic composite materials by hot pressing. Compos. Part B Eng. 2019, 179, 107431. [Google Scholar] [CrossRef]
- Jia, W.; Kharraz, J.A.; Choi, P.J.; Guo, J.; Deka, B.J.; An, A.K. Superhydrophobic membrane by hierarchically structured PDMS-POSS electrospray coating with cauliflower-shaped beads for enhanced MD performance. J. Membr. Sci. 2020, 597, 117638. [Google Scholar] [CrossRef]
- Sarkar, D.K.; Farzaneh, M.; Paynter, R.W. Superhydrophobic properties of ultrathin rf-sputtered Teflon films coated etched aluminum surfaces. Mater. Lett. 2008, 62, 1226–1229. [Google Scholar] [CrossRef]
- Xu, P.; Li, X. Fabrication of TiO2/SiO2 superhydrophobic coating for efficient oil/water separation. J. Environ. Chem. Eng. 2021, 9, 105538. [Google Scholar] [CrossRef]
- Barati Darband, G.; Aliofkhazraei, M.; Khorsand, S.; Sokhanvar, S.; Kaboli, A. Science and engineering of superhydrophobic surfaces: Review of corrosion resistance, chemical and mechanical stability. Arab. J. Chem. 2020, 13, 1763–1802. [Google Scholar] [CrossRef]
- Parvate, S.; Dixit, P.; Chattopadhyay, S. Superhydrophobic surfaces: Insights from theory and experiment. J. Phys. Chem. B 2020, 124, 1323–1360. [Google Scholar] [CrossRef]
- Lin, N.; Berton, P.; Moraes, C.; Rogers, R.D.; Tufenkji, N. Nanodarts, nanoblades, and nanospikes: Mechano-bactericidal nanostructures and where to find them. Adv. Colloid Interface Sci. 2018, 252, 55–68. [Google Scholar] [CrossRef]









| Layers | WCA | WSA |
| 1 | 156.72° ± 1.01° | 2.64° ± 0.55° |
| 3 | 157.01° ± 1.76° | 2.01° ± 0.15° |
| 5 | 157.49° ± 1.07° | 2.21° ± 0.17° |
| 7 | 159.92° ± 1.03° | 2.13° ± 0.61° |
| After 35 days of outdoor exposure | ||
| Layers | WCA | WSA |
| 1 | 159.78° ± 1.07° | 2.91° ± 0.10° |
| 3 | 160.50° ± 1.17° | 2.27° ± 0.29° |
| 5 | 157.60° ± 1.05° | 2.17° ± 0.94° |
| 7 | 160.75° ± 1.01° | 2.94° ± 0.71° |
| Escherichia coli 24 h | Staphylococcus aureus 24 h | Escherichia coli 48 h | Staphylococcus aureus 48 h | |
|---|---|---|---|---|
| 7 L and 5 L | ![]() | ![]() | ![]() | ![]() |
| 3 L and 1 L | ![]() | ![]() | ![]() | ![]() |
Disclaimer/Publisher’s Note: The statements, opinions and data contained in all publications are solely those of the individual author(s) and contributor(s) and not of MDPI and/or the editor(s). MDPI and/or the editor(s) disclaim responsibility for any injury to people or property resulting from any ideas, methods, instructions or products referred to in the content. |
© 2024 by the authors. Licensee MDPI, Basel, Switzerland. This article is an open access article distributed under the terms and conditions of the Creative Commons Attribution (CC BY) license (https://creativecommons.org/licenses/by/4.0/).
Share and Cite
Sánchez-Santamaria, B.; Cornejo-Monroy, D.; Olivas-Armendáriz, I.; Arias-Cerón, J.S.; Villanueva-Montellano, A.; Ordoñez-Casanova, E.; Dávalos-Ramírez, J.O.; Martínez-Gómez, E.A.; Jaquez-Muñoz, J.M. Antibacterial Activity of Superhydrophobic-SiO2 Coatings to Inhibit the Growth of Escherichia coli and Staphylococcus aureus. Coatings 2024, 14, 1211. https://doi.org/10.3390/coatings14091211
Sánchez-Santamaria B, Cornejo-Monroy D, Olivas-Armendáriz I, Arias-Cerón JS, Villanueva-Montellano A, Ordoñez-Casanova E, Dávalos-Ramírez JO, Martínez-Gómez EA, Jaquez-Muñoz JM. Antibacterial Activity of Superhydrophobic-SiO2 Coatings to Inhibit the Growth of Escherichia coli and Staphylococcus aureus. Coatings. 2024; 14(9):1211. https://doi.org/10.3390/coatings14091211
Chicago/Turabian StyleSánchez-Santamaria, Betania, Delfino Cornejo-Monroy, Imelda Olivas-Armendáriz, José Saúl Arias-Cerón, Alfredo Villanueva-Montellano, Elsa Ordoñez-Casanova, José Omar Dávalos-Ramírez, Erwin Adán Martínez-Gómez, and Jesús Manuel Jaquez-Muñoz. 2024. "Antibacterial Activity of Superhydrophobic-SiO2 Coatings to Inhibit the Growth of Escherichia coli and Staphylococcus aureus" Coatings 14, no. 9: 1211. https://doi.org/10.3390/coatings14091211
APA StyleSánchez-Santamaria, B., Cornejo-Monroy, D., Olivas-Armendáriz, I., Arias-Cerón, J. S., Villanueva-Montellano, A., Ordoñez-Casanova, E., Dávalos-Ramírez, J. O., Martínez-Gómez, E. A., & Jaquez-Muñoz, J. M. (2024). Antibacterial Activity of Superhydrophobic-SiO2 Coatings to Inhibit the Growth of Escherichia coli and Staphylococcus aureus. Coatings, 14(9), 1211. https://doi.org/10.3390/coatings14091211